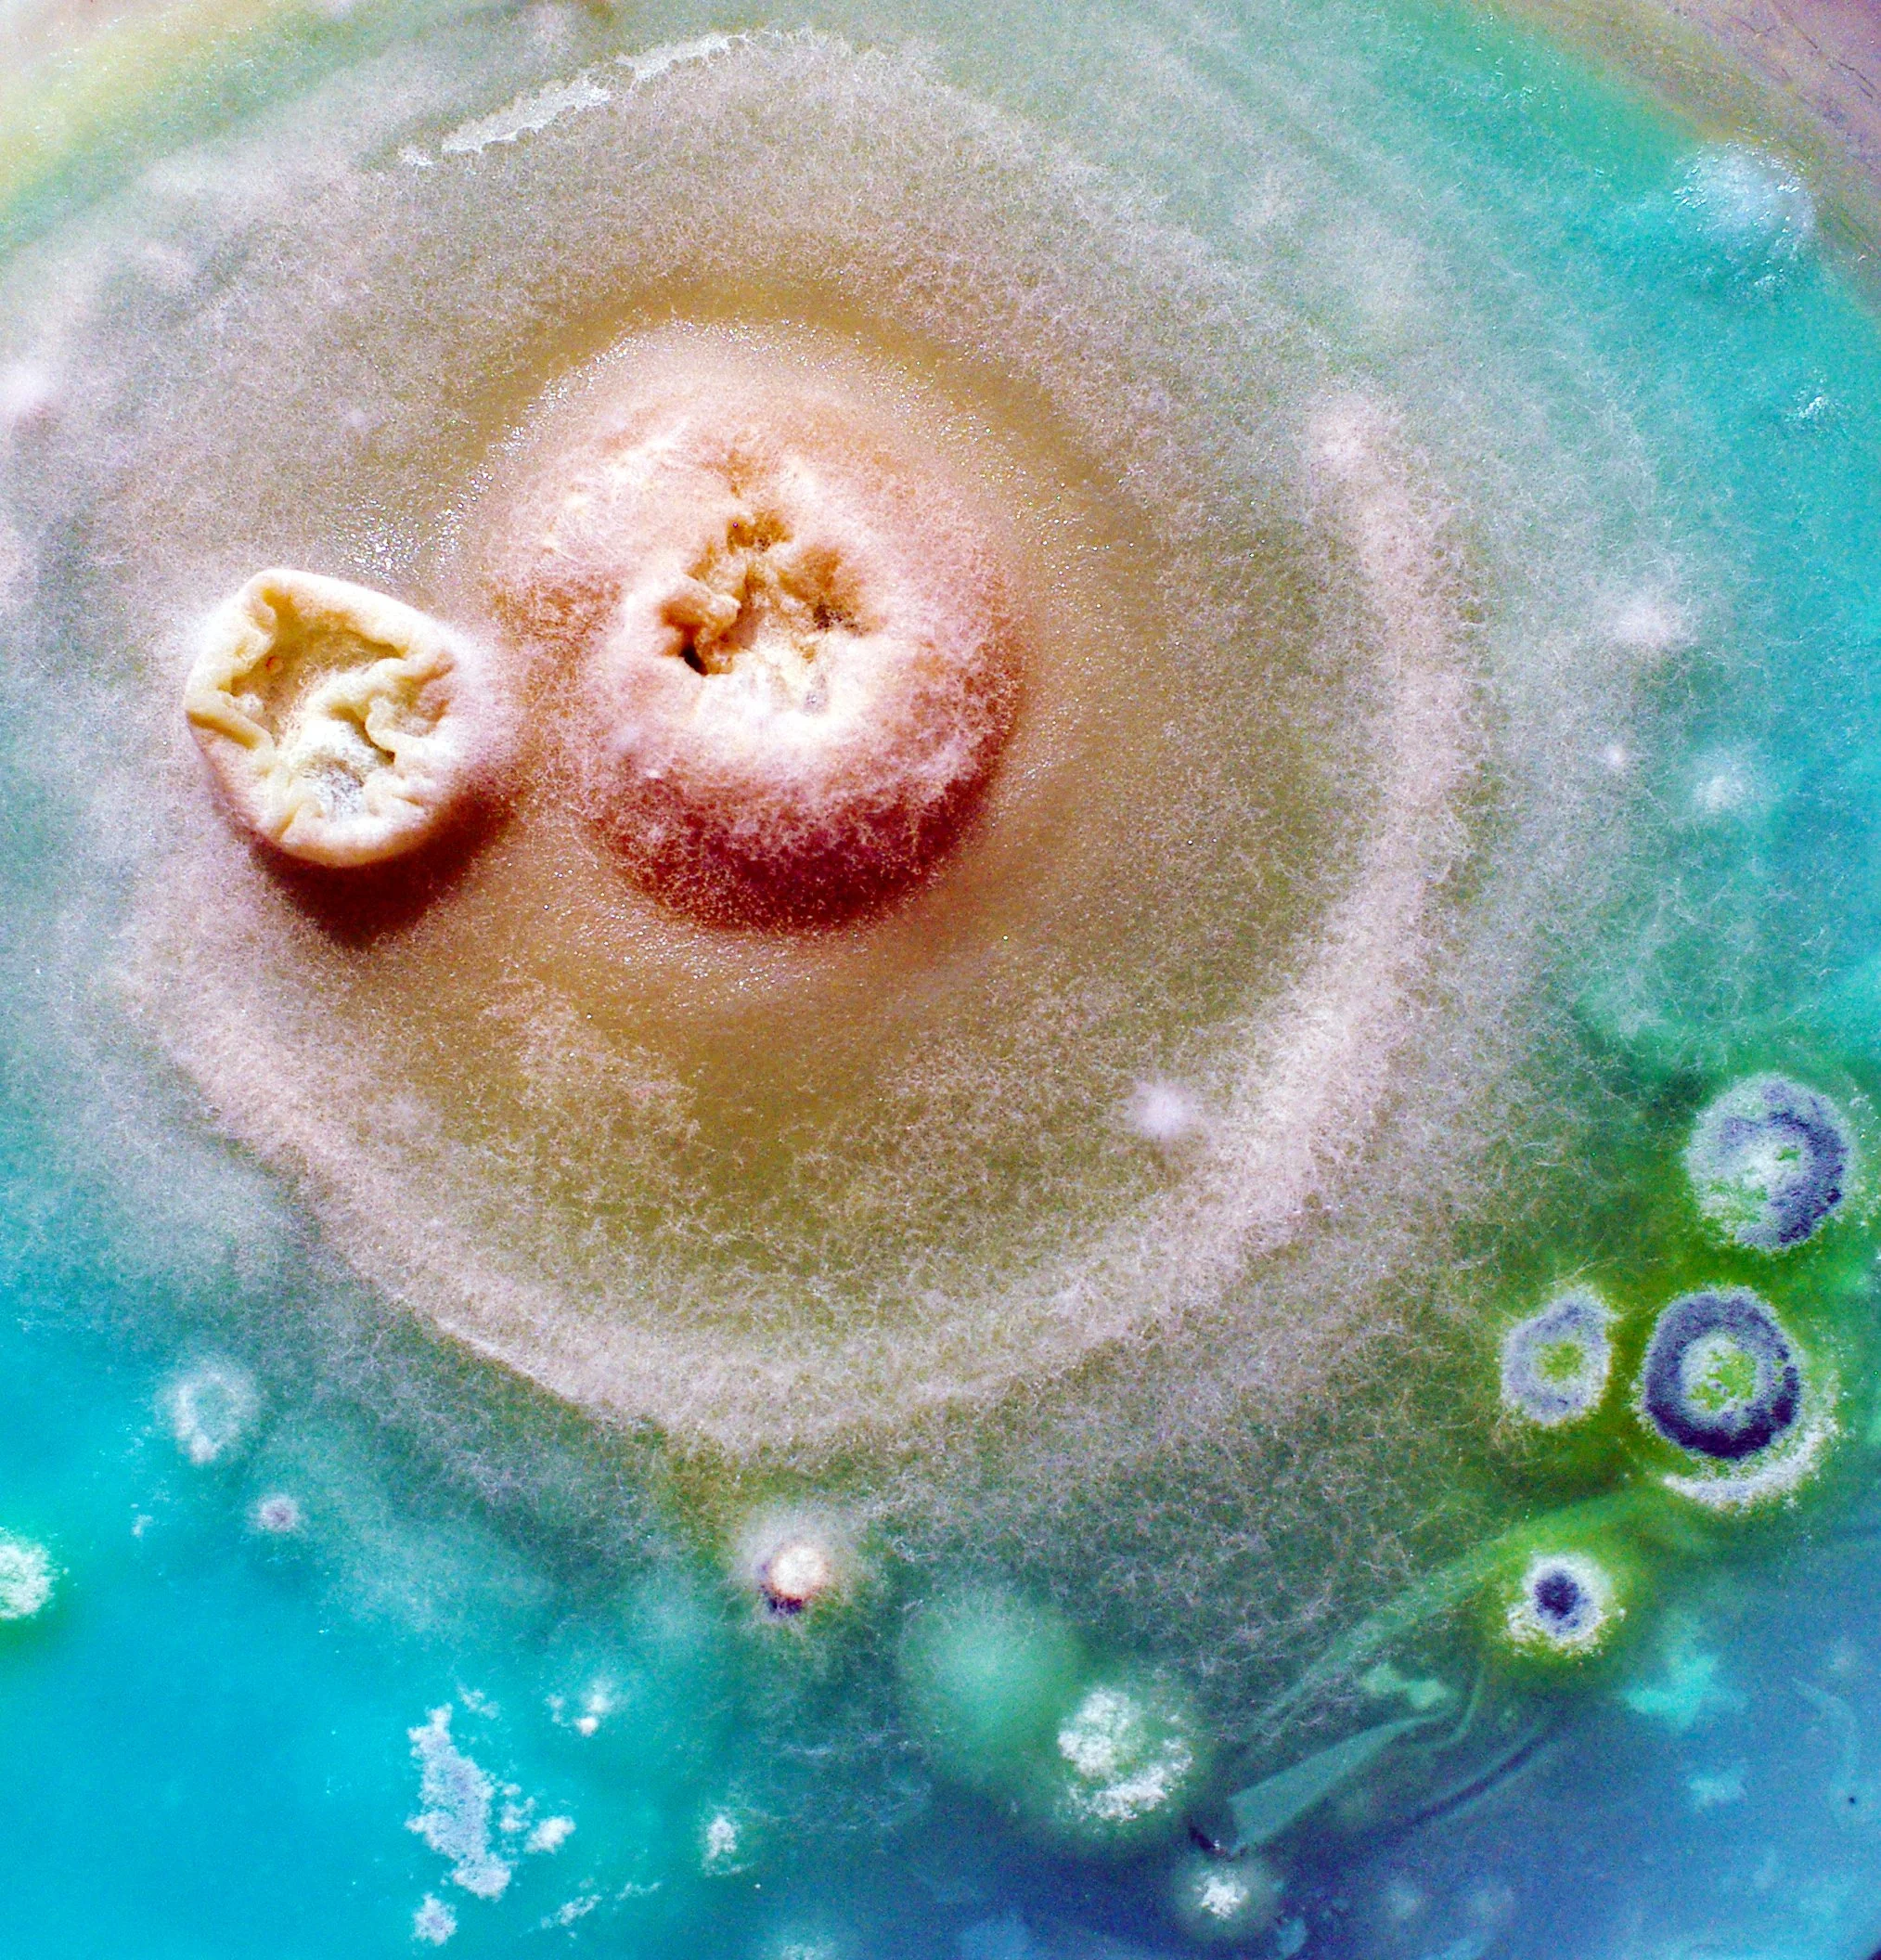

Spores and Mould

That time I grew mould and spores in a Petri dish. I think it looks like a nip too...
I am a stock photographer for Adobe Stock, Shutterstock, Alamy and others with over 20000 images. Links are on my profile page! Let me know if you need something specific, I may well have it!
#stockphotography #photooftheday #photographer #closeupphotography #stockphotographer #stockphoto #adobestock #shutterstock
#naturephotography #mould #spores #naturephotography